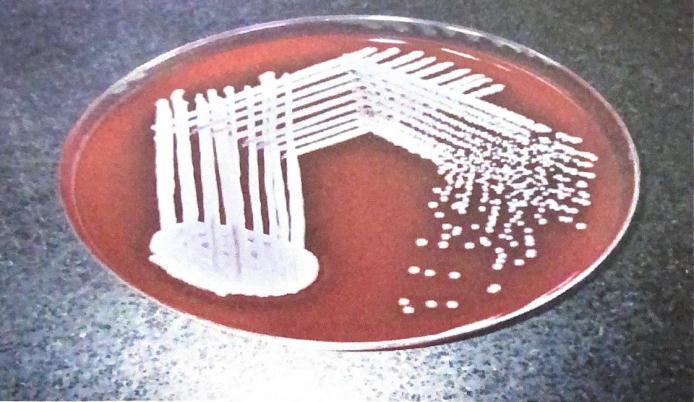
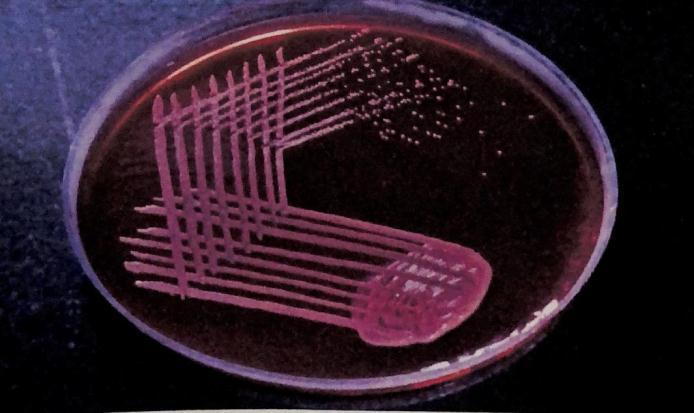

International Research Journal of Engineering and Technology (IRJET) e ISSN: 2395 0056

Volume: 09 Issue: 06 | Jun 2022 www.irjet.net p ISSN: 2395 0072

International Research Journal of Engineering and Technology (IRJET) e ISSN: 2395 0056

Volume: 09 Issue: 06 | Jun 2022 www.irjet.net p ISSN: 2395 0072
2
1Student, Department of Environmental Engineering, MCET, Desamangalam 679532, Kerala, India
2Professor, Department of Environmental Engineering, MCET, Desamangalam 679532, Kerala, India ***
Abstract – Staphylococcus aureus is a bacteria responsible for human infection, and it is highly infectious and resistant to antibiotics. Staphylococcus aureus bacteria give rise to simple skin wound infections to life threatening diseases. Even the presence of this bacterium in drinking water is also a prime concern because of its potential to cause water contamination and human infection. Staphylococcus bacteria also have the ability to cause food poisoning. The major problem about this bacterium is its resistance to antibiotics. MRSA and MSSA are the two types of staphylococcus aureus mostly found. MRSA is methicillin resistant staphylococcus aureus and MSSA is methicillin sensitive staphylococcus aureus. This gram positive bacterium enters the water when it gets highly polluted due to runoffs and fecal matters of human beings and animals. This project deals with detection of presence of s. aureus in various clinical and water sample in order to determine the suitable antibiotic as well the disinfectant to eliminate them from water body.
Staphylococcus aureus is round shaped, gram positive bacteriathatcanbenormallyfoundintheupperrespiratory tractandontheskin.Thebacteriastaphylococcusaureusis onesuchharmfulbacteriumwhichhastheabilitytoinfect humanbeings,actasafoodpoisoningagentwhenpresentin foodandalsohasthepotentialtocontaminatewaterwhen presentinthem.
Polluted water contains e coli normally in them. Similarly staphylococcus aureus can alsobeseen in polluted water. Presenceofthesebacteriainwaterisquitecommonduring rainyseason.
Presence of staphylococcus aureus can be seen in several medical samples such as blood, stool, throat swab, nose swab,urine.
Hencethedetectionofthesebacteriaattheearliestisvery necessary to cure diseases and infections caused by them andalsototakenecessaryremedialmeasurestoeliminate thepresenceinwatersourcestomakethemfitforuse.
Staphylococcusaureusisoftwotypes:MRSAandMSSA.
MethicillinresistantstaphylococcusaureusorMRSAis the staphylococcus aureus bacterium that is resistant to methicillin antibiotics. Infection caused by MRSA is very difficulttotreatsinceitishighlyresistanttoantibiotics.
MSSA orMethicillinsensitive staphylococcus aureus isthe staph bacteria which is sensitive to methicillin and other antibiotics AsaresultdiseasescausedbyMSSAcanbeeasily cured.ComparedtoMRSA,MSSAisnoninfectious.
Table -1: ComparisonbetweenMRSAandMSSA
Aspect MRSA MSSA
Definition staphylococcus aureusthatare methicillin resistant
staphylococcus aureusthatare susceptibleto methicillin
Resistanttomany antibiotic Sensitive to antibiotic treatment Bacterial response Resistantto methicillin Sensitiveto methicillin
Effective responseto antibiotic treatment
Virulence Highlyinfectious Lessinfectious Mortalityrate High Low Preferred treatment Onlyvancomycin Antibioticssuchas cephalexin, amoxylinetc.
Staphylococcus aureus is present everywhere around us. Spreadofthesebacteriaiscommonfromhospitals,clinics, untidy surface etc. These bacteria are not only present in clinicalsamplesbutalsoinwater.
Staphylococcus aureus is present in polluted water. Its presenceissimilartothatofe coli.Staphylococcusaureus canbeseeninwaterespeciallyduringrainyseason.
Waterbodygetscontaminatedwithstaphylococcusaureus bacteriawhenthewaterishighlypollutedwith:
Fecesfrominfectedhumansandanimals
Excesssurfacerunoff
Sewageoverflows
International Research Journal of Engineering and Technology (IRJET) e ISSN: 2395 0056

Volume: 09 Issue: 06 | Jun 2022 www.irjet.net p ISSN: 2395 0072
Waterbodies such as wells, ponds etc. are highly prone to contaminationbythesebacteriaduetolessturbulenceand flow of water. Even private wells during rainy season sometimes show the presence of staphylococcus aureus bacteriaduetoexcessivesurfacerunofffromdifferentareas.
Since staphylococcus aureus can easily enter the water bodiesduetocontaminationofwaterandalsoduringheavy rainyseasonitisveryvitaltodisinfectthewatersourceto makethewaterfitforuse.
Disinfection is the process of killing undesirable bacteria. Disinfectants are the substance used to carry out the processes which are basically chemicals. Quantity of disinfectantusedisusuallyexpressedinmg/lorppm.One mg/lequalsoneppm.
There are several methods of disinfection. Disinfection by bleaching powder, hydrogen peroxide and sodium hypochloriteareadoptedhere.
Bleachingpowderisapaleyellowishpowderwithsmellof chlorine which is a combination of lime and chlorine It usually consists of more than 33% chlorine content. This chlorinecontentisresponsibleforthedisinfectionaction.
The most effective and commonly adopted method of disinfectingwellistousebleachingpowder.Todisinfecta wellnearly100to200gmofbleachingpowderisrequired. Even if the well is highly polluted 200gm of bleaching powderisfarenough,theoptimumdosageofthebleaching powder.
Disinfection by sodium hypochlorite is also another chlorination method. It is also known as bleach. It is a yellowish solution which is very effective in disinfecting watersource.Ithasastrongsmell.Itissometimesusedto removeodouraswell.
Disinfectionbyhydrogenperoxideisanothertechniquethat canbeadoptedforwelldisinfection.Itisacolourlessliquid easily available in market. Its dosage rate is as 1 part of disinfectantto2partsofwatersample.
Since staphylococcus aureus bacteria are virulent, its presenceshouldbedetectedattheearliesttotakenecessary preventive measures. Staphylococcus aureus are seen in clinical samples as well as in polluted water. In order to determinethesuitableantibioticsforprescriptionpurpose, varioussamplesmustbecollectedfromtheinfectedpatients
and it must be cultured by applying suitable medium to detectthepresenceofthebacteria.
Similarlysuspiciouswatersamplesmustalsobecollectedin ordertodeterminethepresenceofstaphylococcusaureus bacteria and to analyze the suitable preventive measures. Followingarethestepscarriedouttoprecedetheproject:
3.
15 clinical samples were collected from hospitals from differentpatientswhichincludesamplesofskinwound,pus, stool,urine,nasalswabandthroatswab.
Watersamplewascollectedfromapublicwelllocatedina denselypopulatedcolony.
Boththeclinicalandwatersampleisthentestedtodetect thepresenceofstaphylococcusaureusinthem.
The staphylococcus aureus is to be isolated from the differentclinicalsamples,preparesmearandgramstaining is carried out to determine whether it is gram positive or negative. The samples were inoculated into sterile MacConkey agar and blood agar. Inoculated plates are incubatedat37degreecelciusfor24hours.Inbloodagarthe medium is prepared by adding sterile blood to sterile nutrientagarmedium,autoclavedandcooledto45degree celciusandthenappropriateamountofbloodispoured.The concentrationofbloodusedis8%
InMacConkeyagarthemediumispreparedbysuspending the components like peptone, agar, bile salt, lactose, and neutral red in distilled water. Mix well, sterilize and autoclaveat121degreecelsiusfor15minutes,coolto45 50 degreecelsius,mixwellanddispenseontoplates.Theplates arethenlefttosolidifyanddry.Bacterialcolonywilldevelop on the slide when sufficient nutrient medium is provided. Gramstainingprocedureisthencarriedoutwitheachtype ofcolonyobtainedinbloodagarandMacConkeyagar.Ifthe bacteriaaregrampositive,catalasetestandcoagulasetest areperformedtodetecttheorganism.
Gram staining procedure is carried out to determine whetherthebacteriaisgrampositiveorgramnegative.The
International Research Journal of Engineering and Technology (IRJET) e ISSN: 2395 0056

Volume: 09 Issue: 06 | Jun 2022 www.irjet.net p ISSN: 2395 0072
procedureisbasedonthereactionbetweenpeptidoglycanin thecellwallsofsomebacteria.Inthebeginningthebacteria is stained with crystal violet where both the positive and negative bacteria will stain to purple colour. It is then treatedwithGram'siodine(iodineandpotassiumiodide),a mordantor fixative. Thegram positivecells wouldform a crystal violet iodine complex. Alcohol or acetone is then appliedtodecolorizethecells.Gram negativebacteriawill becomecolourless,whileonlysomeofthecolourisremoved fromgram positivecells.Thelaststepinvolvestheusageof acounterstain(safranin)tocolourthebacteriapink.Both gram positiveandnegativebacteriapickupthepinkstain.If theprocedureisperformedwell,gram positivebacteriawill be purple in colour while gram negative bacteria will be pink.
Catalase test is used to demonstrate the presence of an enzymenamedcatalasethatcatalyzesthereleaseofoxygen from H2O2. The testis performedona slide.A drop of3% hydrogen peroxide is placed on the slide and an isolated colony is picked up with a sterile stick and placed on this slidecontaining3%hydrogenperoxide.Itisthenobserved immediatelyforactivebubbling.
Coagulase test is the most important test to identify or confirm a bacteria whether it is staphylococcus aureus or not. It can be carried out in two ways, either as slide coagulasetest(SCT)orTubecoagulasetest(TCT).Coagulase isanenzymelikeproteinwhichhastheabilitytoclotplasma byconvertingfibrinogentofibrin.
In slide test, over a glass slide a drop of normal saline is placedoneachend.Emulsifyacolonyofthetestorganismin eachofthedropstomakeathicksuspension.Addplasmato oneofthesuspensionandtheotheristakenascontrol,mix gently. Observe for clumping of the organism within 10 seconds.
Tocarryouttubecoagulasetest,theplasmaisdilutedas1in 10inphysiologicalsaline(mix0.2mlofplasmawith1.8ml of saline). Pipette out 0.5 ml each into three test tubes labelled as T (Test), P (Positive control) and N (Negative control).Testis18 24hrbrothcultureconsistingof5drops oftestorganismwhereaspositivecontrolcontains5dropsof S.aureusbrothcultureandnegativecontrolcontains5drops ofsterilebroth. Incubatethethreetubesfor35 37OC.Itis thenexaminedforclottingafter1hr.
After the detection of staphylococcus aureus in clinical samples as well as water sample, it is necessary to apply suitable remedial measures in order to kill the bacteria presentinthem.
Inthecaseofclinicalsamples,thedetectionofstaphbacteria helpsthedoctortoprescribethesuitableantibioticstothe infected person which helps to cure the disease at the earliest.
In the case of water sample, after the detection of the presenceofthebacteria,disinfectionprocessiscarriedout tomakethewellwaterfitforuse.Twotypesofdisinfection methodsareavailabletodisinfectstaphbacteria.Theyare:
Disinfectionusingchemicals
Disinfectionusingnaturalagents
2.4.1 Disinfection using chemicals
In this method, three chemicals are chosen to disinfect staphylococcusaureusbacteria.Theyare: i.Disinfectionusingbleachingpowder
Thewellsampleistreatedwithbleachingpowdertodetect whetheritcandisinfectthesampleornot.
Take1000mlofthewatersample.
Take5gofbleachingpowder
Makeathickpasteusingwaterfreefromimpurities
Add100mlofwatertothepaste
Stirthemixturethoroughly
Allowthesolutiontorest
A supernatant solution forms leaving behind a residue.
Pourthissolutiontothewatersample.
TestforthepresenceorabsenceofS.aureus
Fig 1: Bleachingpowder

International Research Journal of Engineering and Technology (IRJET) e ISSN: 2395 0056

Volume: 09 Issue: 06 | Jun 2022 www.irjet.net p ISSN: 2395 0072

Procedure:

Take1000mlofthewatersample
100ml of NaOCl solution is added to the sample taken 5%concentratedsodiumhypochloriteisused.
Shakewellthedisinfectantandwatersample
Testforthepresence/absenceofs.aureusbacteria.
2.4.2
Staphylococcus aureus can be disinfected not only by chemicalsbutalsobynaturalagentssuchasturmeric,ginger and garlic. Though usages of chemical disinfectants are effective,thesenaturalitemsalsohavethepotentialtokill staphbacteria.
Curcuminpresentinturmericisthemainfactorthatinhibits the bacterial growth. They are well known for their antibacterialproperty.Here,turmericinpowderedformis usedasdisinfectanttokillstaphbacteria
Procedure:
1000mlwatersampleistaken
100gofturmericpowderismadeintofinepaste.
Procedure:
Take1000mlwatersample
Take500mlofH2O2 solution
Commonlyavailablehydrogenperoxideis3%w/v whichisstableandeffective
1partofdisinfectantshouldbeaddedto2partsof water sample, the dosage rate of hydrogen peroxide.

Mixthoroughlythesampleanddisinfectant.
Allowtorestformorethan15mins.
Testforthepresence/absenceofstaphbacteria.
Makesuretherearenolumps.
Mix the fine paste thoroughly with the water sample.
Allowtorestforfewhours.
TestforS.aureus
Ginger is one of the most effective antibiotics that can destroy bacteria. Ginger also has the ability to kill staphylococcusbacteria.
Procedure:
Take1000mlofwatersample.
Finelygrind250gofgingertoapaste.
Add the paste to the water sample and mix thoroughly
International Research Journal of Engineering and Technology (IRJET) e ISSN: 2395 0056

Volume: 09 Issue: 06 | Jun 2022 www.irjet.net p ISSN: 2395 0072
Allowtorestformorethan2hours
Testforthepresenceofstaphylococcusbacteria.
Garlicisalsowellknownforitsantimicrobialproperty.From ancient times itself garlic has been used to cure several infectionsandkillbacteria.
Procedure:
Take1000mlofwatersample.
Finelygrind350gofgarlictoapaste.
Addittothewatersample.
Shakewelltoensurethoroughmixing.
Allowtorestformorethan2hours
Testforthepresenceofstaphylococcusbacteria.
Variousclinicalsamplesandthewatersampleweretestedto detectthepresenceofstaphylococcusaureusinthem.The resultsobtainedareas:
Amongthe15clinicalsamplescollected,12sampleswere methicillin sensitive staphylococcus aureus (MSSA) and 3 samples were Methicillin resistant staphylococcus aureus (MRSA)strain.
Similarly,watersamplecollectedfromwellalsoshowedthe presenceofstaphylococcusaureusinit.
Afterinoculationandincubationofthesamplesinbloodagar andMacConkeyagarthecoloniesappearedas:
Onbloodagar:βhemolyticcolonies
WhilegramstainingGrampositivebacteriawillstainpurple colourwhencrystalvioletorprimarystainisapplied.Itstill retainsthecolourofvioletbluewhensafraninisaddedeven afterdecolorizerisapplied.
On MacConkey agar: lactose fermenting colonies (pinkishcolour)
Lactose fermenting and β hemolytic colonies are the characteristicfeaturesofstaphylococcusaureus.
The samples collected turned out to exhibit violet blue colour at the end of procedure which indicates that the samplesaregrampositivecocci.
The gram positive cocci are further analyzed to confirm whetherorganismpresentinthesamplecollectedis
Inthecatalasetesttheslidecontainingwellisolatedcolony andhydrogenperoxidewasobservedimmediatelyforactive bubblingandisdeclaredaspositive.
Inslidecoagulasetest,Clumpingoftheorganismwithin10 minutes must be observed within the suspension. The organism clumped up, hence read as coagulase positive staphylococci.
Similarly,inthetubecoagulasetest,theorganismalongwith salineandplasmaisobservedtoclump.Henceitisregarded ascoagulasepositive.
International Research Journal of Engineering and Technology (IRJET) e ISSN: 2395 0056

Volume: 09 Issue: 06 | Jun 2022 www.irjet.net p ISSN: 2395 0072
Inthecaseofclinicalsamples,theyareculturedinhospitals andclinicstodeterminewhichantibioticcanbeprescribed tocurethediseasescausedbytheconcernedbacterium.
An antibiotic is a type of antimicrobial substance active against bacteria. It is the most important type of antibacterial agent for fighting bacterial infections, and antibioticmedicationsarewidelyusedinthetreatmentand preventionofinfections.
Afterculturing,antibioticsusceptibilityiscarriedoutforthe colony which helps to determine which antibiotic at what dosage must be given to patient in order to cure the concerneddiseaseattheearliest.
Antibiotics such as penicillin, ampicillin, amoxyclav, gentamicinetccanbeusedtocureMSSAvariant.Whereas vancomycinistheonlyantibioticthatiscapabletokillMRSA variantbecauseitishighlyresistanttoallotherantibiotics.
The water sample collected from public well was also cultured to detect the presence of s. aureus in them. The samplecollectedshowedthepresenceforthesame.
Hence it is now necessary to take remedial measures to makethewaterfitforuse.Hencedisinfectionisthesolution tokilltheorganismpresentinthesample.Disinfectionby chemicalsaswellasusingnaturalagentscanbeusedasa remedialmeasuretoeliminatethebacteriainwatertomake itagainfitforhumanconsumption.Theresultsaftertreating thewatersampleswitheachdisinfectantaregivenbelow.
NameOf Disinfectant Water Sample Disinfectant Quantity Action Detected
DisinfectionByChemicals
Bleaching Powder 1000ml 5gm Disinfected
Sodium Hypochlorite 1000ml 100ml Disinfected
Hydrogen Peroxide
1000ml 500ml Disinfected
Turmeric 1000ml 100g Disinfected
Ginger 1000ml 250g Disinfected

Garlic 1000ml 350g Disinfected

From the above two charts it is very clear that bleaching powderandturmericarethedisinfectantsthatareusedin leastquantity.Theotherdisinfectantsarealsoeffectivebut these two are used in lesser amount compared to other disinfectantsandthedesiredresultsareattained.
Inthecaseofdisinfectantwithchemicalsallthethreeused, bleaching powder, sodium hypochlorite or bleach and hydrogenperoxideareeffectivedisinfectants.Butthemost widely used disinfectant for well water disinfection is bleaching powder. This is because whatever the contamination level may be the optimum dosage for bleachingpowderrangesbetween100to200mgwhereas the dosage of the other two disinfectants varies with the intensity of contamination. If the well water is highly pollutedtheamountofdisinfectantusedalsoincreases.
Hence the most effective and widely used disinfectant for wellwaterisbleachingpowder.
International Research Journal of Engineering and Technology (IRJET) e ISSN: 2395 0056

Volume: 09 Issue: 06 | Jun 2022 www.irjet.net p ISSN: 2395 0072
Staphylococcusaureusisavirulentgrampositivebacterium that is capable of causing diseases ranging from simple infectionstodeathcausingdiseasesinhumanbeings.Apart fromtheirinfectiouscapability,thesebacteriaalsohavethe abilitytocausefoodpoisoningwhenpresentinfoodmatter.
Thesebacteriacaneasilybeseeninpollutedwaterbodies such as well, pond etc. where there is high pollution and differentkindofrunoffsreachingthesewatersources.The presenceofthisbacteriaiscommonduringrainyseasondue to low turbulence and lack of flow in well and pond. Consumptionofthiswatercausesdiseasesandinfectionsto humanbeings.
As a result detection of these bacteria at the earliest is importanttodetectthepresenceofthesebacteriainwater aswellasinhumanstoadoptnecessarymeasures.Detection ofstaphylococcusaureusbacteriainclinicalsampleshelpsto determinethepresenceorabsenceofthebacteriuminthe samples collected such as stool, urine, throat swab, nose swab, blood etc. and also helps to determine whether the variantisMSSAorMRSAandhelpstofindoutthesuitable antibiotictocurethem.
Detectionofthesegrampositivebacteriainwatersources helpstoeliminateitspresenceandmakesthewaterfitfor use.
Afterthedetectionofstaph bacteria inwater,disinfection must be carried out to make the sample free of this organism.
Eitherdisinfectionbychemicalsordisinfectionbynatural agentscanbeused.
Disinfection by chemicals includes the usage of bleaching powder, sodium hypochlorite solution and hydrogen peroxide. All the three disinfectants are effective at eliminating organisms present in the well water. But the mostandwidelyuseddisinfectantisbleachingpowder.This isbecauseitischeapandeasilyavailableinthemarket.At thesametimeasmallerquantityofdisinfectantiscapableto remove the entire contamination. Even for highest contaminationlevelinthewellwaterabout100to200gof bleachingpowdercandisinfectthewaterenough.Whereas inthecaseofhydrogenperoxideandsodiumhypochlorite the dosage limit varies with contamination level. Hence when contamination increases the amount of disinfectant used also increases. This limits the usage of these disinfectants. Therefore usage of bleaching powder as disinfectantforwellwaterturnsouttobeeconomical.
Disinfectionbynaturalagentsincludestheusageofturmeric, garlic and ginger. All the three are known for their antimicrobialactivitysinceancienttimes.Herequantityof turmericusedislessfordisinfectioncomparedtogingerand
garlic. Though these products do not pose any harmful effectstotheconsumerstheyarenotwidelyusedespecially for disinfection of well water since a large quantity of turmeric,gingerandgarlicwouldberequiredwhichturns outtobeimpracticableandcostly.
Henceforthedisinfectionofwellwaterwemostcommonly use bleaching powder because of its easy availability, cheapness,efficiencyandlimiteddosage.
[1] NavneetKumarR.Singh(2012)Asurveyonprevalence rate and antibiotic susceptibility test pattern of Methicillin Resistant Staphylococcus aureus (MRSA) isolate from various types of clinical specimen and healthyhospitalstaffascarriers,TheJournalofMedical Science,16(17)
[2] McDonald M (2011) The epidemiology of methicillin resistantstaphylococcusaureus,67:682 5
[3] Mukesh Pal Singh, Shalendra Kumar S (2013) Prevalencerateandantibioticsusceptibilitytest(AST) pattern of methicillin resistant staphylococcus aureus isolates from different clinical specimens of Theerthanakar Mahaveer Hospital, Moradabad, India, International Journal of Current Microbiology and AppliedSciences,2(11):307 314.
[4] Geyse A. C. Santos, Milena Dropa et.al (2020) Staphylococcus aureus and methicillin resistant Staphylococcus aureus (MRSA) in drinking water fountains in urban parks, Journal of Water Health, 18 (5):654 664
[5] Mark and Ramon J Seidler (2018) Staphylococcus in rural drinking water, Applied and environmental microbiology,Vol3